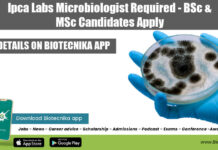
Ipca Labs Microbiologist Required – BSc & MSc Candidates Apply Ipca Labs Microbiology Job

ICMR-RMRCNE Project Jobs With Up To Rs. 54,000 pm Pay For Life Sciences
ICMR-RMRCNE Project Vacancies For Biotech, Bioinformatics & Life Sciences
ICMR-RMRCNE Project Vacancies For Biotech, Bioinformatics & Life Sciences. MSc & PhD Bioinformatics / Biotechnology Jobs....
MAHE Manipal Computational Biology Project Associate Recruitment
MAHE Computational Biology Job - MSc Life Sciences PA Vacancy
MAHE Computational Biology Job - MSc Life Sciences PA Vacancy. Manipal Academy of Higher Education...
IISER Pune DBT/Wellcome Trust India Alliance Life Sciences Research Job
IISER Pune PhD 2022 Vacancy For Life Sciences - Applications Invited
IISER Pune PhD 2022 Vacancy For Life Sciences - Applications Invited. RA Vacancy for...
IISER Kolkata DBT Funded Life Sciences Project Assistant Job Opening
IISER-K Project Job 2022 For Life Sciences, Applications Invited
IISER-K Project Job 2022 For Life Sciences, Applications Invited. MSc Biotech, Zoology, Microbiology, Life Sciences and...
Shell NBS Researcher-Microbial Biogeochemistry Recruitment, Apply Online
Shell Research Jobs 2022 - Soil Microbiology Jobs 2022
Shell Research Jobs 2022 - Soil Microbiology Jobs 2022. Shell Bengaluru PhD Jobs. Soil Microbiology PhD...
Labcorp Life Sciences QA Job, Online Application Process
Labcorp Life Sciences QA Job, Online Application Process
Labcorp Life Sciences QA Job, Online Application Process. QA Auditor II (Pre-clinical-Toxicology) Jobs. Life Sciences QA Auditor...
Novartis Clinical Development Associate Job For MSc & PhD Life Sciences
Novartis Clinical Development Associate Job For Life Sciences
Novartis Clinical Development Associate Job For Life Sciences. Novartis Jobs. Novartis MSc Life Sciences Jobs. Novartis Life...
CSIR NET UNIT 13B – Immunotechniques Revision Notes PDF Download
CSIR NET UNIT 13 Immunotechniques Notes
UNIT 13 is an important unit for The CSIR NET life science exam. Though it's very vast, it is...
Shell PhD Life Sciences Nature Based Solutions Research Recruitment
Shell PhD Life Sciences Nature Based Solutions Research Recruitment
Shell PhD Life Sciences Nature Based Solutions Research Recruitment. Shell Bengaluru PhD Jobs. Life Sciences PhD...
MSc Life Sciences Technician Job at Beckman Coulter – 1-4 Years Exp Candidates Apply...
Beckman Coulter Job Opening For Biotech, Biochem & Life Sciences
Beckman Coulter Job Opening For Biotech, Biochem & Life Sciences. MSc Biotech, Biochem and Life...
DBT/Wellcome Trust India Alliance Senior and Intermediate Fellowships 2022 – Call For Applications
India Alliance Fellowships 2022 - Basic Biomedical Research
The DBT/Wellcome Trust India Alliance (India Alliance, www.indiaalliance.org) invites applications for its Senior and Intermediate Fellowships under the...
Parexel BSc Life Sciences Document Quality Reviewer Recruitment
Parexel Bengaluru Jobs For Life Sciences, Apply Online
Parexel Bengaluru Jobs For Life Sciences, Apply Online. Parexel Hiring Life Sciences For Document Quality Reviewer Vacancy....
Ipca Labs Microbiologist Required – BSc & MSc Candidates Apply
Ipca Labs Microbiology Job - BSc & MSc Candidates Apply
Ipca Labs Microbiology Job - BSc & MSc Candidates Apply. On site job opening. North...
Certificate Course on Clinical Research & Development By Bangalore Bioinnovation Centre & TrialGuna
Clinical R&D Certification Course By Bangalore Bioinnovation Centre & TrialGuna
CERTIFICATE COURSE
CLINICAL RESEARCH DEVELOPMENT
Bangalore Bioinnovation Centre (BBC) in knowledge partnership with Trialguna Pvt. Ltd. is...
SJRI Research Assistant Job For Non-NET MSc Biotech & Biochem Candidates
SJRI Research Assistant Job For MSc Biotech & Biochem Candidates
SJRI Research Assistant Job For MSc Biotech & Biochem Candidates. MSc Biotechnology/ Biochemistry RA vacancy...